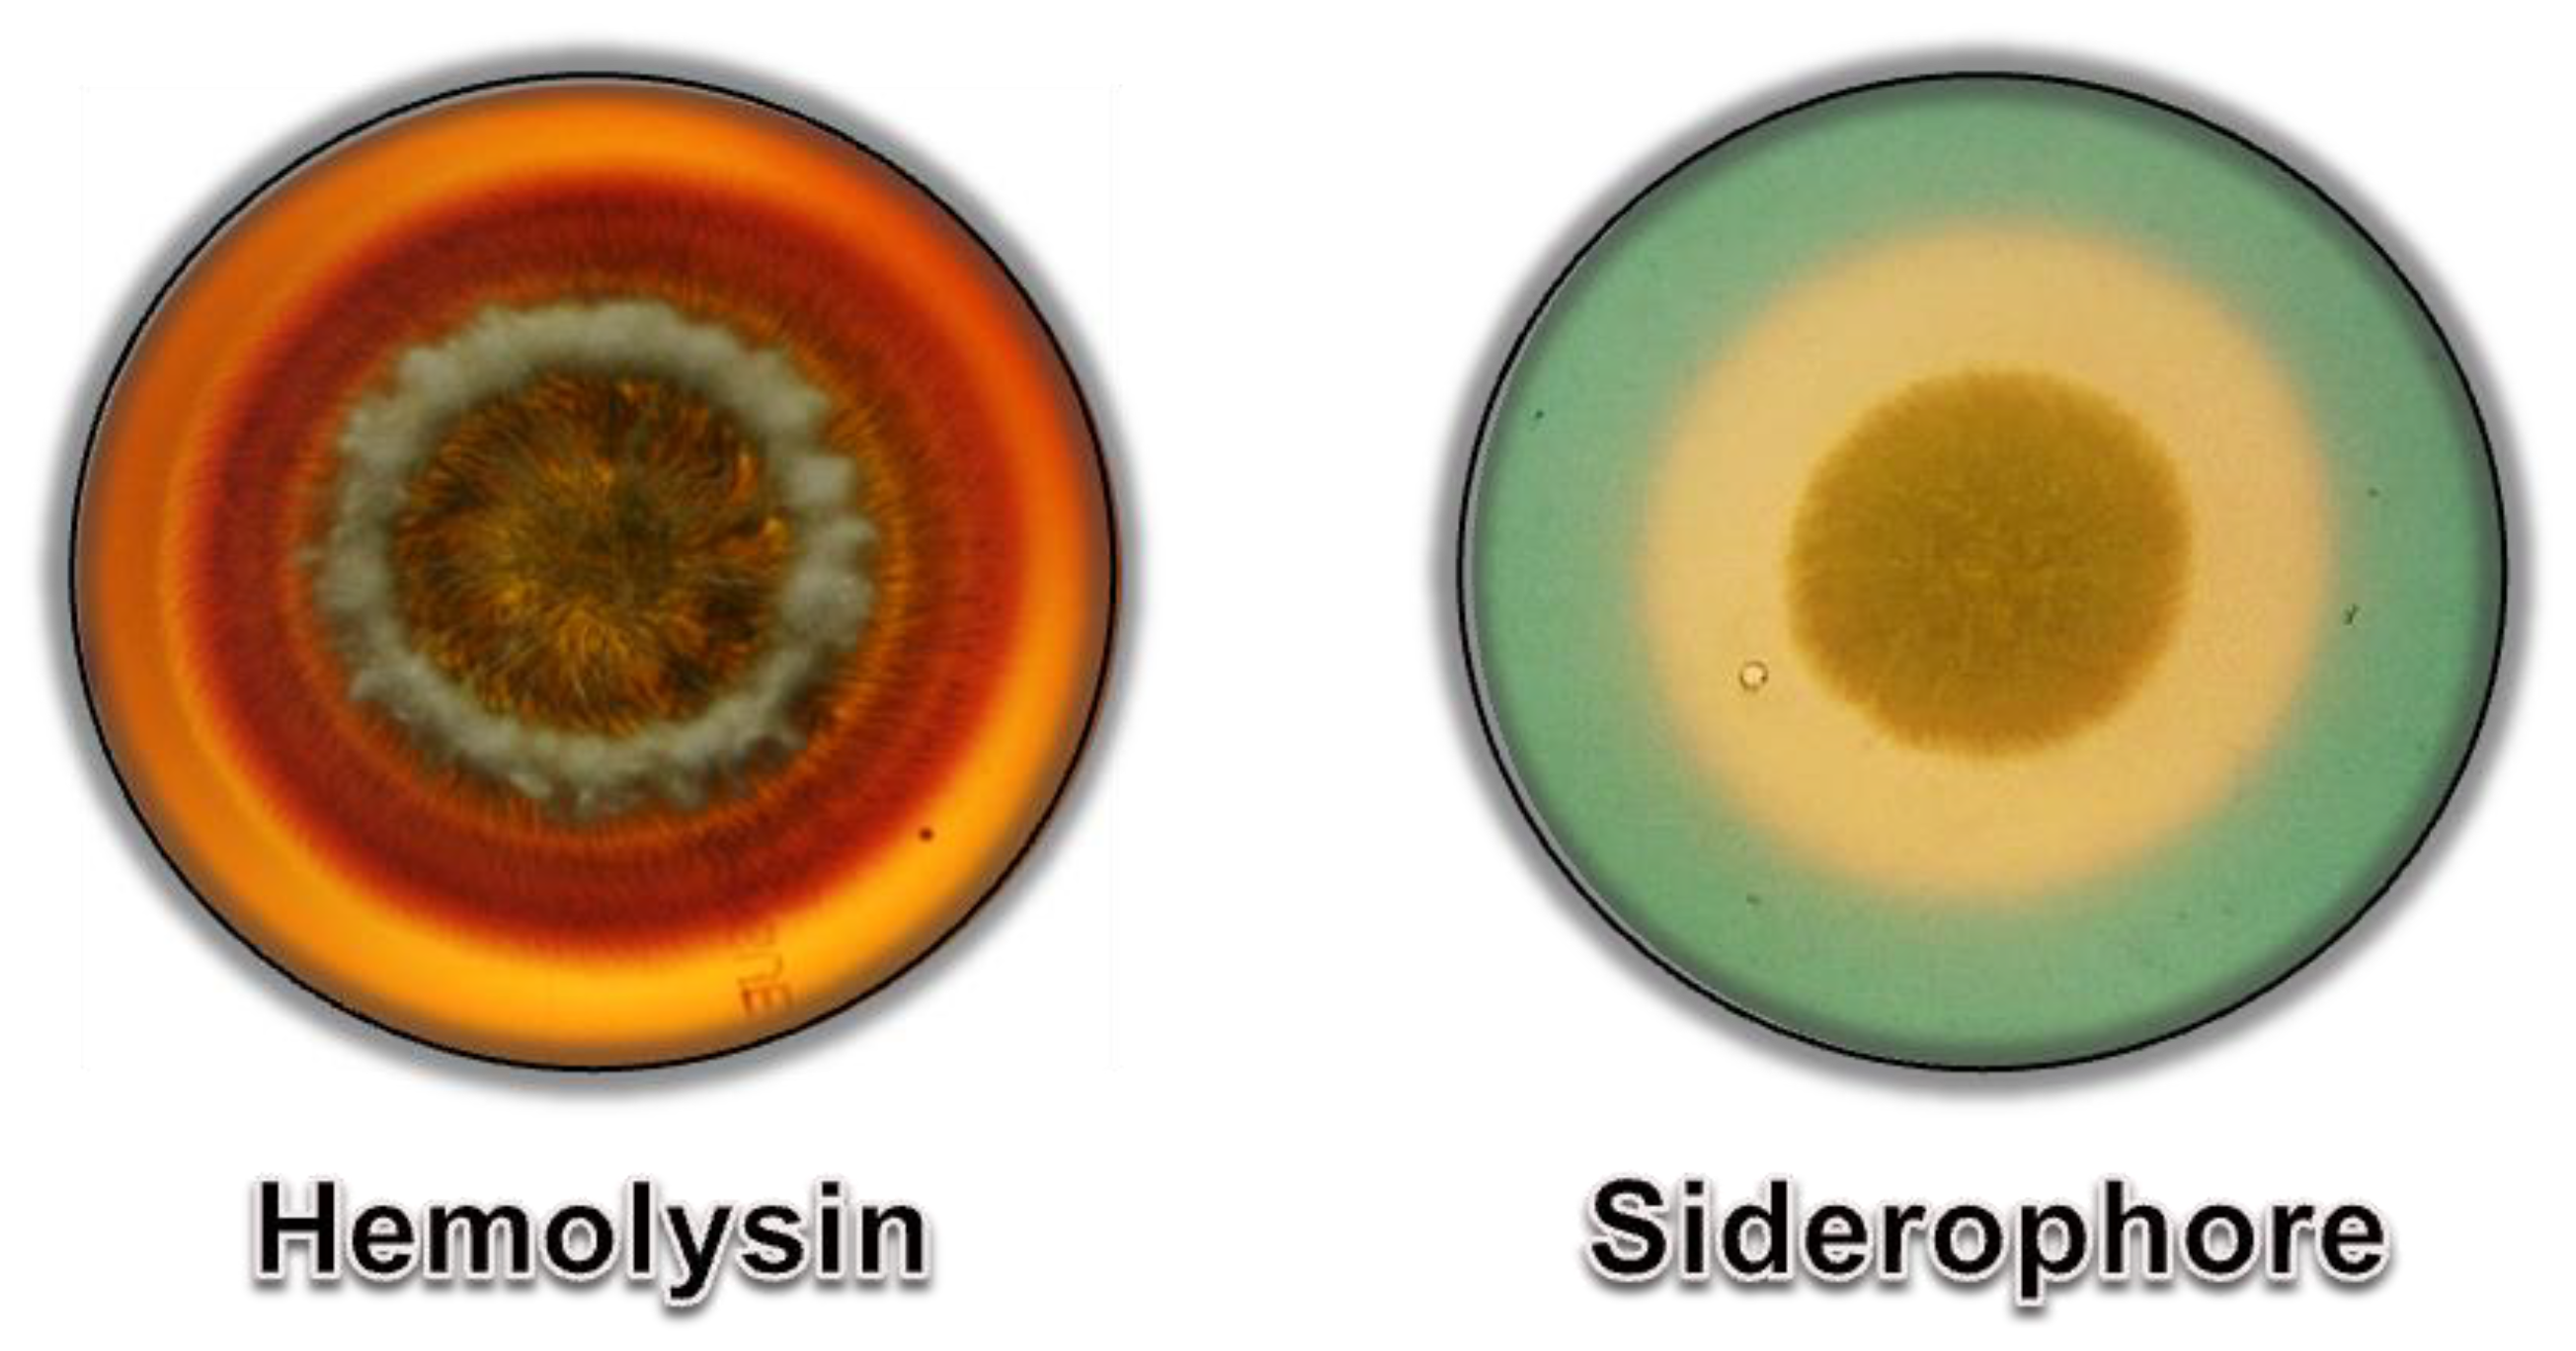
Jof 08 01172 g010

Extracellularly Released Molecules by the Multidrug-Resistant Fungal Pathogens Belonging to the Scedosporium Genus: An Overview Focused on Their Ecological Significance and Pathogenic Relevance
Abstract
1. Introduction: An Overview on the Scedosporium Genus
2. Secretion: An Essential Biological Process in the Fungal Cell Cycle

3. Secretion of Specific Molecules by Scedosporium: Ecological, Physiological and Pathological Perspectives
3.1. Extracellular Vesicles: A Biological Carrier of Active Molecules
3.2. Hydrolytic Enzymes
3.2.1. Peptidases
3.2.2. Lipases
3.2.3. Phosphatases
3.2.4. Detoxifying Enzymes
3.2.5. Mechanisms to Obtain Iron
3.3. Molecules Related to Fungal Diagnosis
3.4. Secondary Metabolites
| Species | Molecule | Activity | References |
|---|---|---|---|
| Scedosporium spp. | AS-183 | Inhibitor of acyl-CoA | [138] |
| S. ellipsoidea | YM-193221 | Antifungal | [134] |
| Scedosporium spp. | Tyroscherin | Antitumor; Antifungal | [122,135,139] |
| Scedosporium spp. | Dehydroxybisdethiobis(methylthio)gliotoxin | Antibacterial | [131] |
| Scedosporium spp. | Bisdethiobis(methylthio)gliotoxin | Antibacterial | [131] |
| Scedosporium spp. | Gliotoxin | Antibacterial | [131] |
| Scedosporium spp. | 12,13-hihydroxyfumitremorgin C | Antibacterial | [132] |
| Scedosporium spp. | Fumitremorgin C | Antibacterial | [132] |
| Scedosporium spp. | Brevianamide F | Antibacterial | [132] |
| Scedosporium spp. | (2RS,8R,10R)-YM-193221 | ND | [139] |
| S. boydii | “Inhibitory substance” | Antifungal | [133] |
| S. boydii | Pseudallin | Antibacterial | [152] |
| S. boydii | Boydone A | Antibacterial | [123,130] |
| S. boydii | Boydone B | Antitumor | [123] |
| S. boydii | Botryorhodine F | ND | [123] |
| S. boydii | Botryorhodine G | ND | [123] |
| S. boydii | Fusidilactone A | ND | [123] |
| S. boydii | (R)-(-)-mevalonolactone | ND | [123] |
| S. boydii | (R)-(-)-lactic acid | ND | [123] |
| S. boydii | Ovalicin | Antitumor | [123] |
| S. boydii | Botryorhodine | ND | [123] |
| S. boydii | N-methyltyroscherin | Antifungal | [135] |
| S. boydii | Boydine A | ND | [140] |
| S. boydii | Boydine B | Antibacterial | [137,140] |
| S. boydii | Boydine C | ND | [140] |
| S. boydii | Boydine D | ND | [140] |
| S. boydii | Boydene A | ND | [140] |
| S. boydii | Boydene B | ND | [140] |
| S. boydii | Pseudaboydin A | ND | [137] |
| S. boydii | Pseudaboydin B | ND | [137] |
| S. boydii | (R)-2-(2-hydroxypropan-2-yl)-2,3-dihydro-5-hydroxybenzofuran | ND | [137] |
| S. boydii | (R)-2-(2-hydroxypropan-2-yl)-2,3-dihydro-5-methoxybenzofuran | ND | [137] |
| S. boydii | 3,3′-dihydroxy-5,5′-dimethyldiphenyl ether | ND | [137] |
| S. boydii | 3-(3-methoxy-5-methylphenoxy)-5-methylphenol | ND | [137] |
| S. boydii | (-)-Regiolone | ND | [137] |
| S. boydii | 6-Chloro-2-(2-hydroxypropan-2-yl)-2,3-dihydro-5-hydroxybenzofuran | ND | [141] |
| S. boydii | 7-Chloro-2-(2-hydroxypropan-2-yl)-2,3-dihydro-5-hydroxybenzofuran | ND | [141] |
| S. ellipsoidea | Pseudellone A | ND | [142] |
| S. ellipsoidea | Pseudellone B | ND | [142] |
| S. ellipsoidea | Pseudellone C | ND | [142,145,146] |
| S. ellipsoidea | Pseudellone D | ND | [145] |
| S. ellipsoidea | (5S,6S)-dihydroxylasiodiplodin | ND | [145] |
| S. ellipsoidea | Lasiodipline F | ND | [145] |
| S. ellipsoidea | (5S)-hydroxylasiodiplodin | ND | [145] |
| S. boydii | Pseuboydone A | ND | [137] |
| S. boydii | Pseuboydone B | ND | [137] |
| S. boydii | Diketopiperazines pseudoboydone C | Insecticidal | [137] |
| S. boydii | Diketopiperazines pseudoboydone D | ND | [137] |
| S. boydii | Haematocin | ND | [137] |
| S. boydii | Phomazine B | ND | [137] |
| S. boydii | Bisdethiobis(methylthio)gliotoxin | ND | [137] |
| S. boydii | Cyclo-(2,20-dimethylthio-Phe-Phe) | ND | [137] |
| S. boydii | Cyclo-(Phe-Phe) | Insecticidal | [137] |
| S. boydii | Ditryptophenaline | ND | [137] |
| S. boydii | Speradine B | ND | [137] |
| S. boydii | Speradine C | ND | [137] |
| S. boydii | Cyclopiamide E | Insecticidal | [137] |
| S. boydii | 24,25-Dehydro-10,11-dihydro-20-hydro- xyaflavinin | Insecticidal | [137] |
| S. boydii | Aflavinine | Insecticidal | [137] |
| S. boydii | b-Aflatrem | ND | [137] |
| S. boydii | Pyripyropene A | ND | [137] |
| S. boydii | Pseudoscherine | ND | [137] |
| S. boydii | 4-(1-Hydroxy-1-methylpropyl)-2-isobutyl-pyrazin-2(1H)-one | ND | [137] |
| S. boydii | 4-(1-Hydroxy-1-methyl-propyl)-2-secbutylpyrazin-2(1H)-one | ND | [137] |
| S. boydii | O-methyl sterigmatocystin | ND | [137] |
| S. boydii | Asperfuran | ND | [137] |
| S. boydii | Pseudallicin A | ND | [147] |
| S. boydii | Pseudallicin B | ND | [147] |
| S. boydii | Pseudallicin C | ND | [147] |
| S. boydii | Pseudallicin D | ND | [147] |
| S. apiospermum | Scedapin A | ND | [148] |
| S. apiospermum | Scedapin B | ND | [148] |
| S. apiospermum | Scedapin C | Antiviral | [148] |
| S. apiospermum | Scedapin D | ND | [148] |
| S. apiospermum | Scedapin E | ND | [148] |
| S. apiospermum | Scequinadoline A | ND | [148] |
| S. apiospermum | Scequinadoline B | ND | [148] |
| S. apiospermum | Scequinadoline C | ND | [148] |
| S. apiospermum | Scequinadoline D | Antiviral | [148] |
| S. apiospermum | Scequinadoline E | ND | [148] |
| S. apiospermum | Scequinadoline F | ND | [148] |
| S. apiospermum | Scequinadoline G | ND | [148] |
| S. boydii | Pseurotin A | Stimulatory osteoclastogenesis | [143] |
| S. boydii | (-)-Ovalicin | Inhibitory osteoclastogenesis | [143] |
| S. boydii | Chlovalicin | ND | [143] |
| S. boydii | Dihydroxybergamotene | ND | [143] |
| S. boydii | AM6898B | Stimulatory osteoclastogenesis | [143] |
| S. boydii | Aspergiketone | ND | [143] |
| S. boydii | Pseudboindole A | ND | [124] |
| S. boydii | Pseudboindole B | ND | [124] |
| S. boydii | 3,3′-Cyclohexylidenebis(1H-indole) | Antitumor | [124] |
| S. boydii | Indole alkaloids | ND | [124] |
| S. boydii | 2-Hydroxy-2-(propan-2-yl) cyclobutane-1,3-dione | ND | [149] |
| S. apiospermum | Scetryptoquivaline A | ND | [125] |
| S. apiospermum | Quinadoline A | Antidiabetic | [125] |
| S. apiospermum | Scequinadoline D | Antidiabetic | [125] |
| S. apiospermum | Scequinadoline E | Antidiabetic | [125] |
| S. apiospermum | Scequinadoline J | Antidiabetic | [125] |
| S. apiospermum | Scequinadoline I | ND | [125] |
| S. apiospermum | Fumiquinazolines | ND | [125] |
3.5. Molecules Involved in Biodegradation
4. Conclusions
Author Contributions
Funding
Institutional Review Board Statement
Informed Consent Statement
Data Availability Statement
Conflicts of Interest
References
- Guarro, J.; Kantarcioglu, A.S.; Horré, E.; Rodriguez-Tudela, J.L.; Estrella, M.C.; Berenguer, J.; Hoog, G.S. Scedosporium apiospermum: Changing clinical spectrum of a therapy-refractory opportunist. Med. Mycol. 2006, 44, 295–327. [Google Scholar] [CrossRef] [PubMed]
- Cortez, K.J.; Roilides, E.; Quiroz-Telles, F.; Meletiadis, J.; Antachopoulos, C.; Knudsen, T.; Buchanan, W.; Milanovich, J.; Sutton, D.A.; Fothergill, A.; et al. Infections caused by Scedosporium spp. Clin. Microbiol. Rev. 2008, 21, 157–197. [Google Scholar] [CrossRef] [PubMed]
- Gilgado, F.; Cano, J.; Gené, J.; Sutton, D.; Guarro, J. Molecular and phenotypic data supporting distinct species statuses for Scedosporium apiospermum and Pseudallescheria boydii and the proposed new species Scedosporium dehoogii. J. Clin. Microbiol. 2008, 46, 766–771. [Google Scholar] [CrossRef] [PubMed]
- Harun, A.; Perdomo, H.; Gilgado, F.; Chen, S.C.; Cano, J.; Guarro, J.; Meyer, W. Genotyping of Scedosporium species: A review of molecular approaches. Med. Mycol. 2009, 47, 406–414. [Google Scholar] [CrossRef] [PubMed][Green Version]
- Kaltseis, J.; Rainer, J.; De Hoog, G.S. Ecology of Pseudallescheria and Scedosporium species in human-dominated and natural environments and their distribution in clinical samples. Med. Mycol. 2009, 47, 398–405. [Google Scholar] [CrossRef]
- Rougeron, A.; Giraud, S.; Alastruey-Izquierdo, A.; Cano-Lira, J.; Rainer, J.; Mouhajir, A.; Le Gal, S.; Nevez, G.; Meyer, W.; Bouchara, J.P. Ecology of Scedosporium species: Present knowledge and future research. Mycopathologia 2018, 183, 185–200. [Google Scholar] [CrossRef]
- Luplertlop, N. Pseudallescheria/Scedosporium complex species: From saprobic to pathogenic fungus. J. Mycol. Med. 2018, 28, 249–256. [Google Scholar] [CrossRef]
- Lackner, M.; de Hoog, S.G.; Yang, L.; Ferreira, M.L.; Ahmed, S.A.; Andreas, F.; Kaltseis, J.; Nagl, M.; Lass-Flörl, C.; Risslegger, B.; et al. Proposed nomenclature for Pseudallescheria, Scedosporium and related genera. Fungal Divers. 2014, 67, 1–10. [Google Scholar] [CrossRef]
- Lamaris, G.; Chamilos, G.; Lewis, R.E.; Safdar, A.; Raad, I.I.; Kontoyiannis, D.P. Scedosporium infection in a tertiary care cancer center: A review of 25 cases from 1989–2006. Clin. Infect. Dis. 2006, 43, 1580–1584. [Google Scholar] [CrossRef]
- Husain, S.; Alexander, B.D.; Munoz, P.; Avery, R.K.; Houston, S.; Pruett, T.; Jacobs, R.; Dominguez, E.A.; Tollemar, J.G.; Baumgarten, K.; et al. Opportunistic mycelial fungal infections in organ transplant recipients: Emerging importance of non-Aspergillus mycelial fungi. Clin. Infect. Dis. 2003, 37, 221–229. [Google Scholar] [CrossRef]
- Husain, S.; Muñoz, P.; Forrest, G.; Alexander, B.D.; Somani, J.; Brennan, K.; Wagener, M.M.; Singh, N. Infections due to Scedosporium apiospermum and Scedosporium prolificans in transplant recipients: Clinical characteristics and impact of antifungal agent therapy on outcome. Clin. Infect. Dis. 2005, 40, 89–99. [Google Scholar] [CrossRef] [PubMed]
- Rodriguez-Tudela, J.L.; Berenguer, J.; Guarro, J.; Kantarcioglu, A.S.; Horre, R.; de Hoog, G.S.; Cuenca-Estrella, M. Epidemiology and outcome of Scedosporium prolificans infection, a review of 162 cases. Med. Mycol. 2009, 47, 359–370. [Google Scholar] [CrossRef] [PubMed]
- Heng, S.C.; Slavin, M.A.; Chen, S.C.; Heath, C.H.; Nguyen, Q.; Billah, B.; Nation, R.L.; Kong, D.C. Hospital costs, length of stay and mortality attributable to invasive scedosporiosis in haematology patients. J. Antimicrob. Chemother. 2012, 67, 2274–2282. [Google Scholar] [CrossRef] [PubMed]
- O’Bryan, T.A. Pseudallescheriasis in the 21st century. Expert Rev. Anti. Infect. Ther. 2005, 3, 765–773. [Google Scholar] [CrossRef]
- Tammer, I.; Tintelnot, K.; Braun-Dullaeus, R.C.; Mawrin, C.; Scherlach, C.; Schlüter, D.; König, W. Infections due to Pseudallescheria/Scedosporium species in patients with advanced HIV disease—A diagnostic and therapeutic challenge. Int. J. Infect. Dis. 2011, 15, e422–e429. [Google Scholar] [CrossRef]
- Kantarcioglu, A.S.; Guarro, J.; de Hoog, G.S. Central nervous system infections by members of the Pseudallescheria boydii species complex in healthy and immunocompromised hosts: Epidemiology, clinical characteristics and outcome. Mycoses 2008, 51, 275–290. [Google Scholar] [CrossRef]
- Noni, M.; Katelari, A.; Kapi, A.; Stathi, A.; Dimopoulos, G.; Doudounakis, S.E. Scedosporium apiospermum complex in cystic fibrosis; should we treat? Mycoses 2017, 60, 594–599. [Google Scholar] [CrossRef]
- Schwarz, C.; Brandt, C.; Whitaker, P.; Sutharsan, S.; Skopnik, H.; Gartner, S.; Smazny, C.; Röhmel, J.F. Invasive pulmonary fungal infections in cystic fibrosis. Mycopathologia 2018, 183, 33–43. [Google Scholar] [CrossRef]
- Bouchara, J.P.; Le Govic, Y.; Kabbara, S.; Cimon, B.; Zouhair, R.; Hamze, M.; Papon, N.; Nevez, G. Advances in understanding and managing Scedosporium respiratory infections in patients with cystic fibrosis. Expert Rev. Respir. Med. 2020, 14, 259–273. [Google Scholar] [CrossRef]
- Ramirez-Garcia, A.; Pellon, A.; Rementeria, A.; Buldain, I.; Barreto-Bergter, E.; Rollin-Pinheiro, R.; de Meirelles, J.V.; Xisto, M.I.D.S.; Ranque, S.; Havlicek, V.; et al. Scedosporium and Lomentospora: An updated overview of underrated opportunists. Med. Mycol. 2018, 56 (Suppl. 1), 102–125. [Google Scholar] [CrossRef]
- Tortorano, A.M.; Richardson, M.; Roilides, E.; van Diepeningen, A.; Caira, M.; Munoz, P.; Johnson, E.; Meletiadis, J.; Pana, Z.D.; Lackner, M.; et al. ESCMID and ECMM joint guidelines on diagnosis and management of hyalohyphomycosis: Fusarium spp., Scedosporium spp. and others. Clin. Microbiol. Infect. 2014, 20 (Suppl. 3), 27–46. [Google Scholar] [CrossRef] [PubMed]
- Mello, T.P.; Bittencourt, V.C.B.; Liporagi-Lopes, L.C.; Aor, A.C.; Branquinha, M.H.; Santos, A.L.S. Insights into the social life and obscure side of Scedosporium/Lomentospora species: Ubiquitous, emerging and multidrug-resistant opportunistic pathogens. Fungal Biol. Rev. 2018, 33, 16–46. [Google Scholar] [CrossRef]
- Mowat, E.; Williams, C.; Jones, B.; McChlery, S.; Ramage, G. The characteristics of Aspergillus fumigatus mycetoma development: Is this a biofilm? Med. Mycol. 2009, 47 (Suppl. 1), S120–S126. [Google Scholar] [CrossRef]
- Mello, T.P.; Aor, A.C.; Gonçalves, D.S.; Seabra, S.H.; Branquinha, M.H.; Santos, A.L.S. Assessment of biofilm formation by Scedosporium apiospermum, S. aurantiacum, S. minutisporum and Lomentospora prolificans. Biofouling 2016, 32, 737–749. [Google Scholar] [CrossRef] [PubMed]
- Mello, T.P.; Oliveira, S.S.C.; Frasés, S.; Branquinha, M.H.; Santos, A.L.S. Surface properties, adhesion and biofilm formation on different surfaces by Scedosporium spp. and Lomentospora prolificans. Biofouling 2018, 34, 800–814. [Google Scholar] [CrossRef]
- Mello, T.P.; Branquinha, M.H.; Santos, A.L.S. Biofilms formed by Scedosporium and Lomentospora species: Focus on the extracellular matrix. Biofouling 2020, 36, 308–318. [Google Scholar] [CrossRef]
- Mello, T.P.; Oliveira, S.S.C.; Branquinha, M.H.; Santos, A.L.S. Decoding the antifungal resistance mechanisms in biofilms of emerging, ubiquitous and multidrug-resistant species belonging to the Scedosporium/Lomentospora genera. Med. Mycol. 2022, 60, myac036. [Google Scholar] [CrossRef]
- Mello, T.P.; Lackner, M.; Branquinha, M.H.; Santos, A.L.S. Impact of biofilm formation and azoles’ susceptibility in Scedosporium/Lomentospora species using an in vitro model that mimics the cystic fibrosis patients’ airway environment. J. Cyst. Fibros. 2021, 20, 303–309. [Google Scholar] [CrossRef]
- Rollin-Pinheiro, R.; de Meirelles, J.V.; Vila, T.V.M.; Fonseca, B.B.; Alves, V.; Frases, S.; Rozental, S.; Barreto-Bergter, E. Biofilm formation by Pseudallescheria/Scedosporium species: A comparative study. Front. Microbiol. 2017, 8, 1568. [Google Scholar] [CrossRef]
- Santos, A.L.S.; Mello, T.P.; Ramos, L.S.; Branquinha, M.H. Biofilm: A robust and efficient barrier to antifungal chemotherapy. J. Antimicrob. Agents 2015, 1, e101. [Google Scholar] [CrossRef]
- Nosanchuk, J.D.; Nimrichter, L.; Casadevall, A.; Rodrigues, M.L. A role for vesicular transport of macromolecules across cell walls in fungal pathogenesis. Commun. Integr. Biol. 2008, 1, 37–39. [Google Scholar] [CrossRef] [PubMed]
- Naglik, J.R.; Challacombe, S.J.; Hube, B. Candida albicans secreted aspartyl peptidases in virulence and pathogenesis. Microbiol. Mol. Biol. Rev. 2003, 67, 400–428. [Google Scholar] [CrossRef] [PubMed]
- Silva, B.A.; Souza-Gonçalves, A.L.; Pinto, M.R.; Barreto-Bergter, E.; Santos, A.L.S. Metallopeptidase inhibitors arrest vital biological processes in the fungal pathogen Scedosporium apiospermum. Mycoses 2011, 54, 105–112. [Google Scholar] [CrossRef] [PubMed]
- Hube, B. Extracellular peptidases of human pathogenic fungi. Contrib. Microbiol. 2000, 5, 126–137. [Google Scholar]
- Silva, B.A.; Sodré, C.L.; Souza-Gonçalves, A.L.; Aor, A.C.; Kneipp, L.F.; Fonseca, B.B.; Rozental, S.; Romanos, M.T.; Sola-Penna, M.; Perales, J.; et al. Proteomic analysis of the secretions of Pseudallescheria boydii, a human fungal pathogen with unknown genome. J. Proteome Res. 2012, 11, 172–188. [Google Scholar] [CrossRef]
- Fontaine, T.; Delangle, A.; Simenel, C.; Coddeville, B.; van Vliet, S.J.; van Kooyk, Y.; Bozza, S.; Moretti, S.; Schwarz, F.; Trichot, C.; et al. Galactosaminogalactan, a new immunosuppressive polysaccharide of Aspergillus fumigatus. PLoS Pathog. 2011, 7, e1002372. [Google Scholar] [CrossRef]
- Miller, M.A.; Greenberger, P.A.; Amerian, R.; Toogood, J.H.; Noskin, G.A.; Roberts, M.; Patterson, R. Allergic bronchopulmonary mycosis caused by Pseudallescheria boydii. Am. Rev. Respir. Dis. 1993, 148, 810–812. [Google Scholar] [CrossRef]
- Osherov, N. Interaction of the pathogenic mold Aspergillus fumigatus with lung epithelial cells. Front. Microbiol. 2012, 3, 346. [Google Scholar] [CrossRef]
- Kogan, T.V.; Jadoun, J.; Mittelman, L.; Hirschberg, K.; Osherov, N. Involvement of secreted Aspergillus fumigatus proteases in disruption of the actin fiber cytoskeleton and loss of focal adhesion sites in infected A549 lung pneumocytes. J. Infect. Dis. 2004, 189, 1965–1973. [Google Scholar] [CrossRef]
- Schindler, B.; Segal, E. Candida albicans metabolite affects the cytoskeleton and phagocytic activity of murine macrophages. Med. Mycol. 2008, 46, 251–258. [Google Scholar] [CrossRef]
- Vandeputte, P.; Ghamrawi, S.; Rechenmann, M.; Iltis, A.; Giraud, S.; Fleury, M.; Thornton, C.; Delhaès, L.; Meyer, W.; Papon, N.; et al. Draft genome sequence of the pathogenic fungus Scedosporium apiospermum. Genome Announc. 2014, 2, e00988-14. [Google Scholar] [CrossRef] [PubMed]
- El-Kamand, S.; Steiner, M.; Ramirez, C.; Halliday, C.; Chen, S.C.-A.; Papanicolaou, A.; Morton, C.O. Assessing differences between clinical isolates of Aspergillus fumigatus from cases of proven invasive aspergillosis and colonizing isolates with respect to phenotype (virulence in Tenebrio molitor larvae) and genotype. Pathogens 2022, 11, 428. [Google Scholar] [CrossRef] [PubMed]
- Lowry, O.H.; Rosebrough, N.J.; Farr, A.L.; Randall, R.J. Protein measurement with the Folin phenol reagent. J. Biol. Chem. 1951, 193, 265–275. [Google Scholar] [CrossRef]
- Wolf, J.M.; Casadevall, A. Challenges posed by extracellular vesicles from eukaryotic microbes. Curr. Opin. Microbiol. 2014, 22, 73–78. [Google Scholar] [CrossRef] [PubMed]
- Zamith-Miranda, D.; Nimrichter, L.; Rodrigues, M.L.; Nosanchuk, J.D. Fungal extracellular vesicles: Modulating host-pathogen interactions by both the fungus and the host. Microbes Infect. 2018, 20, 501–504. [Google Scholar] [CrossRef]
- Rodrigues, M.L.; Franzen, A.J.; Nimrichter, L.; Miranda, K. Vesicular mechanisms of traffic of fungal molecules to the extracellular space. Curr. Opin. Microbiol. 2013, 16, 414–420. [Google Scholar] [CrossRef]
- Casadevall, A.; Nosanchuk, J.D.; Williamson, P.; Rodrigues, M.L. Vesicular transport across the fungal cell wall. Trends Microbiol. 2009, 17, 158–162. [Google Scholar] [CrossRef]
- Brown, L.; Wolf, J.M.; Prados-Rosales, R.; Casadevall, A. Through the wall: Extracellular vesicles in Gram-positive bacteria, mycobacteria and fungi. Nat. Rev. Microbiol. 2015, 13, 620–630. [Google Scholar] [CrossRef]
- Rizzo, J.; Rodrigues, M.L.; Janbon, G. Extracellular vesicles in fungi: Past, present, and future perspectives. Front. Cell. Infect. Microbiol. 2020, 10, 346. [Google Scholar] [CrossRef]
- Rodrigues, M.L.; Nimrichter, L.; Oliveira, D.L.; Frases, S.; Miranda, K.; Zaragoza, O.; Alvarez, M.; Nakouzi, A.; Feldmesser, M.; Casadevall, A. Vesicular polysaccharide export in Cryptococcus neoformans is a eukaryotic solution to the problem of fungal trans-cell wall transport. Eukaryot. Cell 2007, 6, 48–59. [Google Scholar] [CrossRef]
- Albuquerque, P.C.; Nakayasu, E.S.; Rodrigues, M.L.; Frases, S.; Casadevall, A.; Zancope-Oliveira, R.M.; Almeida, I.C.; Nosanchuk, J.D. Vesicular transport in Histoplasma capsulatum: An effective mechanism for trans-cell wall transfer of proteins and lipids in ascomycetes. Cell. Microbiol. 2008, 10, 1695–1710. [Google Scholar] [CrossRef] [PubMed]
- Gehrmann, U.; Qazi, K.R.; Johansson, C.; Hultenby, K.; Karlsson, M.; Lundeberg, L.; Gabrielsson, S.; Scheynius, A. Nanovesicles from Malassezia sympodialis and host exosomes induce cytokine responses—Novel mechanisms for host-microbe interactions in atopic exzema. PLoS ONE 2011, 6, e21480. [Google Scholar] [CrossRef] [PubMed]
- Vallejo, M.C.; Matsuo, A.L.; Ganiko, L.; Medeiros, L.C.S.; Miranda, K.; Silva, L.S.; Freymuller-Haapalainen, E.; Sinigaglia-Coimbra, R.; Almeida, I.C.; Puccia, R. The pathogenic fungus Paracoccidioides brasiliensis exports extracellular vesicles containing highly immunogenic. Eukaryot. Cell 2011, 10, 343–351. [Google Scholar] [CrossRef]
- Silva, B.M.; Prados-Rosales, R.; Espadas-Moreno, J.; Wolf, J.M.; Luque-Garcia, J.L.; Gonçalves, T.; Casadevall, A. Characterization of Alternaria infectoria extracellular vesicles. Med. Mycol. 2014, 52, 202–210. [Google Scholar] [CrossRef] [PubMed]
- Bitencourt, T.A.; Rezende, C.P.; Quaresemin, N.R.; Moreno, P.; Hatanaka, O.; Rossi, A.; Martinez-Rossi, N.M.; Almeida, F. Extracellular vesicles from the dermatophyte Trichophyton interdigitale modulate macrophage and keratinocyte functions. Front. Immunol. 2018, 9, 2343. [Google Scholar] [CrossRef]
- Liu, M.; Bruni, G.O.; Taylor, C.M.; Zhang, Z.; Wang, P. Comparative genome-wide analysis of extracellular small RNAs from the mucormycosis pathogen Rhizopus delemar. Sci. Rep. 2018, 8, 5243. [Google Scholar] [CrossRef]
- De Paula, R.G.; Antoniêto, A.C.C.; Nogueira, K.M.V.; Ribeiro, L.F.C.; Rocha, M.C.; Malavazi, I.; Almeida, F.; Silva, R.N. Extracellular vesicles carry cellulases in the industrial fungus Trichoderma reesei. Biotechnol. Biofuels 2019, 12, 146. [Google Scholar] [CrossRef]
- Souza, J.A.M.; Baltazar, L.M.; Carregal, V.M.; Gouveia-Eufrasio, L.; Oliveira, A.G.; Dias, W.G.; Rocha, M.C.; Miranda, K.R.; Malavazi, I.; Santos, D.A.; et al. Characterization of Aspergillus fumigatus extracellular vesicles and their effects on macrophages and neutrophils functions. Front. Microbiol. 2019, 10, 2008. [Google Scholar] [CrossRef]
- Brauer, V.S.; Pessoni, A.M.; Bitencourt, T.A.; De Paula, R.G.; De Oliveira, R.L.; Goldman, G.H.; Almeida, F. Extracellular vesicles from Aspergillus flavus induce M1 polarization in vitro. mSphere 2020, 5, e00190-20. [Google Scholar] [CrossRef]
- Rizzo, J.; Chaze, T.; Miranda, K.; Roberson, R.W.; Gorgette, O.; Nimrichter, L.; Matondo, M.; Latgé, J.P.; Beauvais, A.; Rodrigues, M.L. Characterization of extracellular vesicles produced by Aspergillus fumigatus protoplasts. mSphere 2020, 5, e00476-20. [Google Scholar] [CrossRef]
- Rodrigues, M.L.; Nakayasu, E.S.; Oliveira, D.L.; Nimrichter, L.; Nosanchuk, J.D.; Almeida, I.C.; Casadevall, A. Extracellular vesicles produced by Cryptococcus neoformans contain protein components associated with virulence. Eukaryot. Cell 2008, 7, 58–67. [Google Scholar] [CrossRef] [PubMed]
- Rodrigues, M.L.; Nakayasuc, E.S.; Almeida, I.C.; Nimrichter, L. The impact of proteomics on the understanding of functions and biogenesis of fungal extracellular vesicles. J. Proteom. 2014, 97, 177–186. [Google Scholar] [CrossRef] [PubMed]
- Vargas, G.; Rocha, J.D.; Oliveira, D.L.; Albuquerque, P.C.; Frases, S.; Santos, S.S.; Nosanchuk, J.D.; Gomes, A.M.; Medeiros, L.C.; Miranda, K.; et al. Compositional and immunological analyses of extracellular vesicles released by Candida albicans. Cell. Microbiol. 2014, 17, 389–407. [Google Scholar] [CrossRef] [PubMed]
- Oliveira, D.L.; Freire-De-Lima, C.G.; Nosanchuk, J.D.; Casadevall, A.; Rodrigues, M.L.; Nimrichter, L. Extracellular vesicles from Cryptococcus neoformans modulate macrophage functions. Infect. Immun. 2011, 78, 1601–1609. [Google Scholar] [CrossRef] [PubMed]
- Aor, A.C. Moléculas Secretadas por Pseudallescheria boydii: Detecção, Antigenicidade e Efeitos na Biologia de Células Hospedeiras. Master’s Thesis, Universidade Federal do Rio de Janeiro, Rio de Janeiro, Brazil, 2013. [Google Scholar]
- Santos, A.L.S. Aspartic proteases of human pathogenic fungi are prospective targets for the generation of novel and effective antifungal inhibitors. Curr. Enzyme Inhib. 2011, 7, 96–118. [Google Scholar] [CrossRef]
- Pawar, P.R.; Pawar, V.A.; Aute, R.A. Role of extracellular hydrolytic enzymes in Candida albicans virulence. Int. J. Pharm. Sci. Rev. Res. 2014, 2, 1521–1532. [Google Scholar]
- Silva, R.R. Bacterial and fungal proteolytic enzymes: Production, catalysis and potential applications. Appl. Biochem. Biotechnol. 2017, 183, 1–19. [Google Scholar] [CrossRef]
- Pichová, I.; Pavlícková, L.; Dostál, J.; Dolejsí, E.; Hrusková-Heidingsfeldová, O.; Weber, J.; Ruml, T.; Soucek, M. Secreted aspartic proteases of Candida albicans, Candida tropicalis, Candida parapsilosis and Candida lusitaniae. Inhibition with peptidomimetic inhibitors. Eur. J. Biochem. 2001, 268, 2669–2677. [Google Scholar] [CrossRef]
- Singh, D.K.; Németh, T.; Papp, A.; Tóth, R.; Lukácsi, S.; Heidingsfeld, O.; Dostal, J.; Vágvölgyi, C.; Bajtay, Z.; Józsi, M.; et al. Functional characterization of secreted aspartyl proteases in Candida parapsilosis. mSphere 2019, 4, e00484-19. [Google Scholar] [CrossRef]
- Namvar, S.; Warn, P.; Farnell, E.; Bromley, M.; Fraczek, M.; Bowyer, P.; Herrick, S. Aspergillus fumigatus proteases, Asp f 5 and Asp f 13, are essential for airway inflammation and remodelling in a murine inhalation model. Clin. Exp. Allergy 2015, 45, 982–993. [Google Scholar] [CrossRef]
- Larcher, G.; Cimon, B.; Symoens, F.; Tronchin, G.; Chabasse, D.; Bouchara, J.P. A 33 kDa serine proteinase from Scedosporium apiospermum. Biochem. J. 1996, 126, 119–126. [Google Scholar] [CrossRef] [PubMed]
- Han, Z.; Kautto, L.; Nevalainen, H. Secretion of proteases by an opportunistic fungal pathogen Scedosporium aurantiacum. PLoS ONE 2017, 12, e0169403. [Google Scholar] [CrossRef] [PubMed]
- Han, Z.; Kautto, L.; Meyer, W.; Chen, S.C.A.; Nevalainen, H. Growth and protease secretion of Scedosporium aurantiacum under conditions of hypoxia. Microbiol. Res. 2018, 216, 23–29. [Google Scholar] [CrossRef] [PubMed]
- Silva, B.A.; Pinto, M.R.; Soares, R.M.; Barreto-Bergter, E.; Santos, A.L.S. Pseudallescheria boydii releases metallopeptidases capable of cleaving several proteinaceous compounds. Res. Microbiol. 2006, 157, 425–432. [Google Scholar] [CrossRef] [PubMed]
- Silva, B.A.; Santos, A.L.S.; Barreto-Bergter, E.; Pinto, M.R. Extracellular peptidase in the fungal pathogen Pseudallescheria boydii. Curr. Microbiol. 2006, 53, 18–22. [Google Scholar] [CrossRef]
- Pereira, M.M.; Silva, B.A.; Pinto, M.R.; Barreto-Bergter, E.; Santos, A.L.S. Proteins and peptidases from conidia and mycelia of Scedosporium apiospermum strain HLPB. Mycopathologia 2009, 167, 25–30. [Google Scholar] [CrossRef]
- Palmeira, V.F.; Kneipp, L.F.; Alviano, C.S.; Santos, A.L.S. The major chromoblastomycosis fungal pathogen, Fonsecaea pedrosoi, extracellularly releases proteolytic enzymes whose expression is modulated by culture medium composition: Implications on the fungal development and cleavage of key’s host structures. FEMS Immunol. Med. Microbiol. 2006, 46, 21–29. [Google Scholar] [CrossRef]
- Han, Z.; Kautto, L.; Meyer, W.; Chen, S.C.; Nevalainen, H. Effect of peptidases secreted by the opportunistic pathogen Scedosporium aurantiacum on human epithelial cells. Can. J. Microbiol. 2019, 65, 814–822. [Google Scholar] [CrossRef]
- Mello, T.P.; Barcellos, I.; Branquinha, M.H.; Santos, A.L.S. Hydrolytic enzymes (proteases and lipases) released by biofilm-forming cells of Scedosporium/Lomentospora species. J. Microbiol. Exp. 2019, 7, 62–65. [Google Scholar]
- Singh, A.K.; Mukhopadhyay, M. Overview of fungal lipase: A review. Appl. Biochem. Biotechnol. 2012, 166, 486–520. [Google Scholar] [CrossRef]
- Park, M.; Do, E.; Jung, W.H. Lipolytic enzymes involved in the virulence of human pathogenic fungi. Mycobiology 2013, 41, 67–72. [Google Scholar] [CrossRef] [PubMed]
- Cazarolli, J.C.; Guzatto, R.; Samios, D.; Peralba, M.C.R.; Cavalcanti, E.H.S.; Bento, F.M. Susceptibility of linseed, soybean, and olive biodiesel to growth of the deteriogenic fungus Pseudallescheria boydii. Inter. Biodet. Biod. 2014, 95, 364–372. [Google Scholar] [CrossRef]
- Boelter, G.; Cazarolli, J.C.; Beker, S.A.; de Quadros, P.D.; Correa, C.; Ferrão, M.F.; Galeazzi, C.F.; Pizzolato, T.M.; Bento, F.M. Pseudallescheria boydii and Meyerozyma guilliermondii: Behavior of deteriogenic fungi during simulated storage of diesel, biodiesel, and B10 blend in Brazil. Environ. Sci. Pollut. Res. Int. 2018, 25, 30410–30424. [Google Scholar] [CrossRef] [PubMed]
- Pinto, M.R.; de Sá, A.C.M.; Limongi, C.L.; Rozental, S.; Santos, A.L.S.; Barreto-Bergter, E. Involvement of peptidorhamnomannan in the interaction of Pseudallescheria boydii and HEp2 cells. Microbes Infect. 2004, 6, 1259–1267. [Google Scholar] [CrossRef]
- Aor, A.C.; Mello, T.P.; Sangenito, L.S.; Fonseca, B.B.; Rozental, S.; Lione, V.F.; Veiga, V.F.; Branquinha, M.H.; Santos, A.L.S. Ultrastructural viewpoints on the interaction events of Scedosporium apiospermum conidia with lung and macrophage cells. Mem. Inst. Oswaldo Cruz. 2018, 113, e180311. [Google Scholar] [CrossRef]
- Mello, T.P.; Aor, A.C.; Branquinha, M.H.; Santos, A.L.S. Insights into the interaction of Scedosporium apiospermum, Scedosporium aurantiacum, Scedosporium minutisporum, and Lomentospora prolificans with lung epithelial cells. Braz. J. Microbiol. 2019, 51, 427–436. [Google Scholar] [CrossRef]
- Elizondo-Zertuche, M.; Montoya, A.M.; Robledo-Leal, E.; Garza-Veloz, I.; Sánchez-Núñez, A.L.; Ballesteros-Elizondo, R.; González, G.M. Comparative pathogenicity of Lomentospora prolificans (Scedosporium prolificans) isolates from Mexican patients. Mycopathologia 2017, 182, 681–689. [Google Scholar] [CrossRef]
- Albataineh, M.T.; Kadosh, D. Regulatory roles of phosphorylation in model and pathogenic fungi. Med. Mycol. 2016, 54, 333–352. [Google Scholar] [CrossRef]
- Kiffer-Moreira, T.; Pinheiro, A.A.S.; Pinto, M.R.; Esteves, F.F.; Souto-Padrón, T.; Barreto-Bergter, E.; Meyer-Fernandes, J.R. Mycelial forms of Pseudallescheria boydii present ectophosphatase activities. Arch. Microbiol. 2007, 188, 159–166. [Google Scholar] [CrossRef]
- Fernanado, P.H.; Panagoda, G.J.; Samaranayake, L.P. The relationship between the acid and alkaline phosphatase activity and the adherence of clinical isolates of Candida parapsilosis to human buccal epithelial cells. APMIS 1999, 107, 1034–1042. [Google Scholar] [CrossRef]
- Bom, V.L.; de Castro, P.A.; Winkelströter, L.K.; Marine, M.; Hori, J.I.; Ramalho, L.N.; dos Reis, T.F.; Goldman, M.H.; Brown, N.A.; Rajendran, R.; et al. The Aspergillus fumigatus sitA phosphatase homologue is important for adhesion, cell wall integrity, biofilm formation, and virulence. Eukaryot. Cell 2015, 14, 728–744. [Google Scholar] [CrossRef]
- Staerck, C.; Yaakoub, H.; Vandeputte, P.; Tabiasco, J.; Godon, C.; Gastebois, A.; Giraud, S.; Guillemette, T.; Calenda, A.; Delneste, Y.; et al. The Glycosylphosphatidylinositol-anchored superoxide dismutase of Scedosporium apiospermum protects the conidia from oxidative stress. J. Fungi 2021, 7, 575. [Google Scholar] [CrossRef] [PubMed]
- Lima, O.C.; Larcher, G.; Vandeputte, P.; Lebouil, A.; Chabasse, D.; Simoneau, P.; Bouchara, J.P. Molecular cloning and biochemical characterization of a Cu,Zn-superoxide dismutase from Scedosporium apiospermum. Microbes Infect. 2007, 9, 558–565. [Google Scholar] [CrossRef] [PubMed]
- Mina, S.; Staerck, C.; d’Almeida, S.M.; Marot, A.; Delneste, Y.; Calenda, A.; Tabiasco, J.; Bouchara, J.P.; Fleury, M.J.J. Identification of Scedosporium boydii catalase A1 gene, a reactive oxygen species detoxification factor highly expressed in response to oxidative stress and phagocytic cells. Fungal Biol. 2015, 119, 1322–1333. [Google Scholar] [CrossRef] [PubMed]
- Mina, S.; Marot-Leblond, A.; Cimon, B.; Fleury, M.J.; Larcher, G.; Bouchara, J.P.; Robert, R. Purification and characterization of a mycelial catalase from Scedosporium boydii, a useful tool for specific antibody detection in patients with cystic fibrosis. Clin. Vaccine Immunol. 2015, 22, 37–45. [Google Scholar] [CrossRef]
- Staerck, C.; Tabiasco, J.; Godon, C.; Delneste, Y.; Bouchara, J.P.; Fleury, M.J.J. Transcriptional profiling of Scedosporium apiospermum enzymatic antioxidant gene battery unravels the involvement of thioredoxin reductases against chemical and phagocytic cells oxidative stress. Med. Mycol. 2019, 57, 363–373. [Google Scholar] [CrossRef]
- Bertrand, S.; Larcher, G.; Landreau, A.; Richomme, P.; Duval, O.; Bouchara, J.P. Hydroxamate siderophores of Scedosporium apiospermum. Biometals 2009, 22, 1019–1029. [Google Scholar] [CrossRef] [PubMed]
- Ramos, L.S.; Figueiredo-Carvalho, M.H.G.; Silva, L.N.; Siqueira, N.L.M.; Lima, J.C.; Oliveira, S.S.; Almeida-Paes, R.; Zancopé-Oliveira, R.M.; Azevedo, F.S.; Ferreira, A.L.P.; et al. The threat called Candida haemulonii species complex in Rio de Janeiro State, Brazil: Focus on antifungal resistance and virulence attributes. J. Fungi 2022, 8, 574. [Google Scholar] [CrossRef] [PubMed]
- Riddell, J., 4th; Chenoweth, C.E.; Kauffman, C.A. Disseminated Scedosporium apiospermum infection in a previously healthy woman with HELLP syndrome. Mycoses 2004, 47, 442–446. [Google Scholar] [CrossRef] [PubMed]
- Bertrand, S.; Bouchara, J.P.; Venier, M.C.; Richomme, P.; Duval, O.; Larcher, G. N(α)-methyl coprogen B, a potential marker of the airway colonization by Scedosporium apiospermum in patients with cystic fibrosis. Med. Mycol. 2010, 48 (Suppl. 1), S98–S107. [Google Scholar] [CrossRef]
- Le Govic, Y.; Havlíček, V.; Capilla, J.; Luptáková, D.; Dumas, D.; Papon, N.; Le Gal, S.; Bouchara, J.P.; Vandeputte, P. Synthesis of the hydroxamate siderophore Nα-Methylcoprogen B in Scedosporium apiospermum is mediated by sidD ortholog and is required for virulence. Front. Cell. Infect. Microbiol. 2020, 10, 587909. [Google Scholar] [CrossRef]
- Thornton, C.R. Tracking the emerging human pathogen Pseudallescheria boydii by using highly specific monoclonal antibodies. Clin. Vaccine Immunol. 2009, 16, 756–764. [Google Scholar] [CrossRef]
- Kaufman, L.; Standard, P.G.; Jalbert, M.; Kraft, D.E. Immunohistologic identification of Aspergillus spp. and other hyaline fungi by using polyclonal fluorescent antibodies. J. Clin. Microbiol. 1997, 35, 2206–2209. [Google Scholar] [CrossRef]
- Jabado, N.; Casanova, J.L.; Haddad, E.; Dulieu, F.; Fournet, J.C.; Dupont, B.; Fischer, A.; Hennequin, C.; Blanche, S. Invasive pulmonary infection due to Scedosporium apiospermum in two children with chronic granulomatous disease. Clin. Infect. Dis. 1998, 27, 1437–1441. [Google Scholar] [CrossRef][Green Version]
- Pinto, M.R.; Mulloy, B.; Haido, R.M.; Travassos, L.R.; Barreto-Bergter, E. A peptidorhamnomannan from the mycelium of Pseudallescheria boydii is a potential diagnostic antigen of this emerging human pathogen. Microbiology 2001, 147, 1499–1506. [Google Scholar] [CrossRef]
- Xisto, M.I.; Bittencourt, V.C.; Liporagi-Lopes, L.C.; Haido, R.M.T.; Mendonça, M.S.A.; Sassaki, G.; Figueiredo, R.T.; Romanos, M.T.; Barreto-Bergter, E. O-Glycosylation in cell wall proteins in Scedosporium prolificans is critical for phagocytosis and inflammatory cytokines production by macrophages. PLoS ONE 2015, 10, e0123189. [Google Scholar] [CrossRef]
- Oliveira, E.B.; Xisto, M.I.D.S.; Rollin-Pinheiro, R.; Rochetti, V.P.; Barreto-Bergter, E. Peptidorhamnomannans from Scedosporium and Lomentospora species display microbicidal activity against bacteria commonly present in cystic fibrosis patients. Front. Cell. Infect. Microbiol. 2020, 10, 598823. [Google Scholar] [CrossRef]
- Meirelles, J.V.; Xisto, M.I.D.D.S.; Rollin-Pinheiro, R.; Serrato, R.V.; Haido, R.M.T.; Barreto-Bergter, E. Peptidorhamanomannan: A surface fungal glycoconjugate from Scedosporium aurantiacum and Scedosporium minutisporum and its recognition by macrophages. Med. Mycol. 2021, 59, 441–452. [Google Scholar] [CrossRef]
- Lopes, L.C.; Rollin-Pinheiro, R.; Guimaraes, A.J.; Bittencourt, V.C.; Martinez, L.R.; Koba, W.; Farias, S.E.; Nosanchuk, J.D.; Barreto-Bergter, E. Monoclonal antibodies against peptidorhamnomannans of Scedosporium apiospermum enhance the pathogenicity of the fungus. PLoS Negl. Trop. Dis. 2010, 4, e853. [Google Scholar] [CrossRef]
- Pavlaskova, K.; Nedved, J.; Kuzma, M.; Zabka, M.; Sulc, M.; Sklenar, J.; Novak, P.; Benada, O.; Kofronova, O.; Hajduch, M.; et al. Characterization of pseudacyclins A-E, a suite of cyclic peptides produced by Pseudallescheria boydii. J. Nat. Prod. 2010, 73, 1027–1032. [Google Scholar] [CrossRef]
- Krasny, L.; Strohalm, M.; Bouchara, J.P.; Sulc, M.; Lemr, K.; Barreto-Bergter, E.; Havlicek, V. Scedosporium and Pseudallescheria low molecular weight metabolites revealed by database search. Mycoses 2011, 54 (Suppl. 3), S37–S42. [Google Scholar] [CrossRef] [PubMed]
- Mina, S.; Staerck, C.; Marot, A.; Godon, C.; Calenda, A.; Bouchara, J.P.; Fleury, M.J.J. Scedosporium boydii CatA1 and SODC recombinant proteins, new tools for serodiagnosis of Scedosporium infection of patients with cystic fibrosis. Diagn. Microbiol. Infect. Dis. 2017, 89, 282–287. [Google Scholar] [CrossRef] [PubMed]
- Karageorgopoulos, D.E.; Vouloumanou, E.K.; Ntziora, F.; Michalopoulos, A.; Rafailidis, P.I.; Falagas, M.E. β-D-glucan assay for the diagnosis of invasive fungal infections: A meta-analysis. Clin. Infect. Dis. 2011, 52, 750–770. [Google Scholar] [CrossRef] [PubMed]
- Chen, S.C.; Halliday, C.L.; Hoenigl, M.; Cornely, O.A.; Meyer, W. Scedosporium and Lomentospora Infections: Contemporary microbiological tools for the diagnosis of invasive disease. J. Fungi 2021, 7, 23. [Google Scholar] [CrossRef]
- Cuerara, M.S.; Alhambra, A.; Moragues, M.; Gonzalez-Elorza, E.; Ponton, J.; de Palacio, A. Detection of (1,2)-β-D-glucan as an adjunct to diagnosis in a mixed population with uncommon proven invasive fungal diseases or with an unusual clinical presentation. Clin. Vaccine. Immunol. 2009, 16, 423–426. [Google Scholar]
- Levesque, E.; Rizk, F.; Noorah, Z.; Ait-Ammar, N.; Cordonnier-Jourdin, C.; El-Anbassi, S.; Bonnal, C.; Azoulay, D.; Merle, J.-C.; Botterel, F. Detection of (1,3)-β-D-glucan for the diagnosis of invasive fungal infection in liver transplant recipients. Int. J. Mol. Sci. 2017, 18, 862. [Google Scholar] [CrossRef]
- Nishimori, M.; Takahashi, T.; Suzuki, E.; Kodaka, T.; Hiramoto, N.; Itoh, K.; Tsunemine, H.; Yarita, K.; Kamei, K.; Takegawa, H.; et al. Fatal fungemia with Scedosporium prolificans in a patient with acute myeloid leukemia. Med. Mycol. J. 2014, 55E, E63–E70. [Google Scholar] [CrossRef]
- Keller, N.P. Fungal secondary metabolism: Regulation, function and drug discovery. Nat. Rev. Microbiol. 2019, 17, 167–180. [Google Scholar] [CrossRef]
- Felnagle, E.A.; Jackson, E.E.; Chan, Y.A.; Podevels, A.M.; Berti, A.D.; McMahon, M.D.; Thomas, M.G. Nonribosomal peptide synthetases involved in the production of medically relevant natural products. Mol. Pharm. 2008, 5, 191–211. [Google Scholar] [CrossRef]
- Le Govic, Y.; Papon, N.; Le Gal, S.; Bouchara, J.P.; Vandeputte, P. Non-ribosomal peptide synthetase gene clusters in the human pathogenic fungus Scedosporium apiospermum. Front. Microbiol. 2019, 10, 1–14. [Google Scholar] [CrossRef]
- Hayakawa, Y.; Yamashita, T.; Mori, T.; Nagai, K.; Shin-Ya, K.; Watanabe, H. Structure of tyroscherin, an antitumor antibiotic against IGF-1-dependent cells from Pseudallescheria sp. J. Antibiot. 2004, 57, 634–638. [Google Scholar] [CrossRef] [PubMed][Green Version]
- Chang, Y.C.; Deng, T.S.; Pang, K.L.; Hsiao, C.J.; Chen, Y.Y.; Tang, S.J.; Lee, T.H. Polyketides from the littoral plant associated fungus Pseudallescheria boydii. J. Nat. Prod. 2013, 76, 1796–1800. [Google Scholar] [CrossRef] [PubMed]
- Yuan, M.X.; Qiu, Y.; Ran, Y.Q.; Feng, G.K.; Deng, R.; Zhu, X.F.; Lan, W.J.; Li, H.J. Exploration of indole alkaloids from marine fungus Pseudallescheria boydii F44-1 using an amino acid-directed strategy. Mar. Drugs 2019, 17, 77. [Google Scholar] [CrossRef] [PubMed]
- Li, C.J.; Chen, P.N.; Li, H.J.; Mahmud, T.; Wu, D.L.; Xu, J.; Lan, W.J. Potential antidiabetic fumiquinazoline alkaloids from the marine-derived fungus Scedosporium apiospermum F41-1. J. Nat. Prod. 2020, 83, 1082–1091. [Google Scholar] [CrossRef]
- Silva, L.N.; Mello, T.P.; Ramos, L.S.; Branquinha, M.H.; Santos, A.L.S. Current challenges and updates on the therapy of fungal infections. Curr. Top. Med. Chem. 2019, 19, 495–499. [Google Scholar] [CrossRef] [PubMed]
- Larsson, D.G.J.; Flach, C.F. Antibiotic resistance in the environment. Nat. Rev. Microbiol. 2022, 20, 257–269. [Google Scholar] [CrossRef]
- Arnold, R.S.; Thom, K.A.; Sharma, S.; Phillips, M.; Kristie, J.J.; Morgan, D.J. Emergence of Klebsiella pneumoniae carbapenemase-producing bacteria. South. Med. J. 2011, 104, 40–45. [Google Scholar] [CrossRef]
- Antimicrobial Resistance Collaborators. Global burden of bacterial antimicrobial resistance in 2019: A systematic analysis. Lancet 2022, 399, 629–655. [Google Scholar] [CrossRef]
- Staerck, C.; Landreau, A.; Herbette, G.; Roullier, C.; Bertrand, S.; Siegler, B.; Larcher, G.; Bouchara, J.P.; Fleury, M.J.J. The secreted polyketide boydone A is responsible for the anti-Staphylococcus aureus activity of Scedosporium boydii. FEMS Microbiol. Lett. 2017, 364, fnx223. [Google Scholar] [CrossRef]
- Li, X.; Kim, S.K.; Nam, K.W.; Kang, J.S.; Choi, H.D.; Son, B.W. A new antibacterial dioxopiperazine alkaloid related to gliotoxin from a marine isolate of the fungus Pseudallescheria. J. Antibiot. 2006, 59, 248–250. [Google Scholar] [CrossRef]
- Zhang, D.; Noviendri, D.; Nursid, M.; Yang, X.D.; Son, B.W. 12, 13-Dihydroxyfumitremorgin C, fumitremorgin C, and brevianamide F, antibacterial diketopiperazine alkaloids from the marine-derived fungus Pseudallescheria sp. Nat. Prod. Sci. 2007, 13, 251–254. [Google Scholar]
- Ko, W.H.; Tsou, Y.J.; Ju, Y.M.; Hsieh, H.M.; Ann, P.J. Production of a fungistatic substance by Pseudallescheria boydii isolated from soil amended with vegetable tissues and its significance. Mycopathologia 2010, 169, 125–131. [Google Scholar] [CrossRef] [PubMed]
- Kamigiri, K.; Tanaka, K.; Matsumoto, H.; Nagai, K.; Watanabe, M.; Suzuki, K. YM-193221, a novel antifungal antibiotic produced by Pseudallescheria ellipsoidea. J. Antibiot. 2004, 57, 569–572. [Google Scholar] [CrossRef] [PubMed][Green Version]
- Nirma, C.; Eparvier, V.; Stien, D. Antifungal agents from Pseudallescheria boydii SNB-CN73 isolated from a Nasutitermes sp. termite. J. Nat. Prod. 2013, 76, 988–991. [Google Scholar] [CrossRef]
- Huang, L.H.; Xu, M.Y.; Li, H.J.; Li, J.Q.; Chen, Y.X.; Ma, W.Z.; Li, Y.P.; Xu, J.; Yang, D.P.; Lan, W.J. Amino acid-directed strategy for inducing the marine-derived fungus Scedosporium apiospermum F41-1 to maximize alkaloid diversity. Org. Lett. 2017, 19, 4888–4891. [Google Scholar] [CrossRef]
- Lan, W.J.; Wang, K.T.; Xu, M.Y.; Zhang, J.J.; Lam, C.K.; Zhong, G.H.; Xu, J.; Yang, D.P.; Li, H.; Wang, L.Y. Secondary metabolites with chemical diversity from the marine-derived fungus Pseudallescheria boydii F19-1 and their cytotoxic activity. RSC Adv. 2016, 6, 76206–76213. [Google Scholar] [CrossRef]
- Kuroda, K.; Yoshida, M.; Uosaki, Y.; Ando, K.; Kawamoto, I.; Oishi, E.; Onuma, H.; Yamada, K.; Matsuda, Y. AS-183, a novel inhibitor of acyl-CoA: Cholesterol acyltransferase produced by Scedosporium sp. SPC-15549. J. Antibiot. 1993, 46, 1196–1202. [Google Scholar] [CrossRef]
- Katsuta, R.; Yajima, A.; Ishigami, K.; Nukada, T.; Watanabe, H. Synthesis of (2RS,8R,10R)-YM-193221 and an improved approach to tyroscherin, bioactive natural compounds from Pseudallescheria sp. Biosci. Biotechnol. Biochem. 2010, 74, 2056–2059. [Google Scholar] [CrossRef][Green Version]
- Wu, Q.; Jiang, N.; Han, W.B.; Mei, Y.N.; Ge, M.H.; Guo, Z.K.; Weng, N.S.; Tan, R.X. Antibacterial epipolythiodioxopiperazine and unprecedented sesquiterpene from Pseudallescheria boydii, a beetle (coleoptera)-associated fungus. Org. Biomol. Chem. 2014, 12, 9405–9412. [Google Scholar] [CrossRef]
- Yan, D.F.; Lan, W.J.; Wang, K.T.; Huang, L.; Jiang, C.W.; Li, H.J. Two chlorinated benzofuran derivatives from the marine fungus Pseudallescheria boydii. Nat. Prod. Commun. 2015, 10, 621–622. [Google Scholar] [CrossRef]
- Liu, W.; Li, H.J.; Xu, M.Y.; Ju, Y.C.; Wang, L.Y.; Xu, J.; Yang, D.P.; Lan, W.J. Pseudellones A-C, three alkaloids from the marine-derived fungus Pseudallescheria ellipsoidea F42-3. Org. Lett. 2015, 17, 5156–5159. [Google Scholar] [CrossRef] [PubMed]
- Liu, D.H.; Sun, Y.Z.; Kurtán, T.; Mándi, A.; Tang, H.; Li, J.; Su, L.; Zhuang, C.L.; Liu, Z.Y.; Zhang, W. Osteoclastogenesis regulation metabolites from the coral-associated fungus Pseudallescheria boydii TW-1024-3. J. Nat. Prod. 2019, 82, 1274–1282. [Google Scholar] [CrossRef] [PubMed]
- Wang, D.; Neupane, P.; Ragnarsson, L.; Capon, R.J.; Lewis, R.J. Synthesis of Pseudellone analogs and characterization as novel T-type calcium channel blockers. Mar. Drugs. 2018, 16, 475. [Google Scholar] [CrossRef] [PubMed]
- Wang, K.T.; Xu, M.Y.; Liu, W.; Li, H.J.; Xu, J.; Yang, D.P.; Lan, W.J.; Wang, L.Y. Two additional new compounds from the marine-derived fungus Pseudallescheria ellipsoidea F42-3. Molecules 2016, 21, 442. [Google Scholar] [CrossRef] [PubMed]
- Sathieshkumar, P.P.; Latha, P.; Nagarajan, R. Total synthesis of Pseudellone C. Eur. J. Org. Chem. 2017, 22, 3161–3164. [Google Scholar] [CrossRef]
- Sorres, J.; Nirma, C.; Eparvier, V.; Stien, D. Pseudallicins A-D: Four complex Ovalicin derivatives from Pseudallescheria boydii SNB-CN85. Org. Lett. 2017, 19, 3978–3981. [Google Scholar] [CrossRef]
- Macheleidt, J.; Mattern, D.J.; Fischer, J.; Netzker, T.; Weber, J.; Schroeckh, V.; Valiante, V.; Brakhage, A.A. Regulation and role of fungal secondary metabolites. Annu. Rev. Genet. 2016, 23, 371–392. [Google Scholar] [CrossRef]
- Liao, J.L.; Pang, K.L.; Sun, G.H.; Pai, T.W.; Hsu, P.H.; Lin, J.S.; Sun, K.H.; Hsieh, C.C.; Tang, S.J. Chimeric 6-methylsalicylic acid synthase with domains of acyl carrier protein and methyltransferase from Pseudallescheria boydii shows novel biosynthetic activity. Microb. Biotechnol. 2019, 12, 920–931. [Google Scholar] [CrossRef]
- Bills, G.F.; Gloer, J.B. Biologically active secondary metabolites from the fungi. Microbiol. Spectr. 2016, 4. [Google Scholar] [CrossRef]
- Su, H.J.; Lin, M.J.; Tsou, Y.J.; Ko, W.H. Pseudallin, a new antibiotic produced by the human pathogenic fungus Pseudallescheria boydii, with ecological significance. Bot. Stud. 2012, 53, 239–242. [Google Scholar]
- Deshmukh, R.; Khardenavis, A.A.; Purohit, H.J. Diverse metabolic capacities of fungi for bioremediation. Indian J. Microbiol. 2016, 56, 247–264. [Google Scholar] [CrossRef] [PubMed]
- de Hoog, G.S.; Marvin-Sikkema, F.D.; Lahpoor, G.A.; Gottschall, J.C.; Prins, R.A.; Guého, E. Ecology and physiology of the emerging opportunistic fungi Pseudallescheria boydii and Scedosporium prolificans. Mycoses 1994, 37, 71–78. [Google Scholar] [CrossRef] [PubMed]
- April, T.M.; Abbott, S.P.; Foght, J.M.; Currah, R.S. Degradation of hydrocarbons in crude oil by the ascomycete Pseudallescheria boydii (Microascaceae). Can. J. Microbiol. 1998, 44, 270–278. [Google Scholar] [CrossRef] [PubMed]
- Markovetz, A.J.J.; Cazin, J.; Allen, J.E. Assimilation of alkanes and alkenes by fungi. Appl. Microbiol. 1968, 16, 487–489. [Google Scholar] [CrossRef] [PubMed]
- Clauβen, M.; Schmidt, S. Biodegradation of phenol and p-cresol by the hyphomycete Scedosporium apiospermum. Res. Microbiol. 1998, 149, 399–406. [Google Scholar]
- Clauβen, M.; Schmidt, S. Biodegradation of phenylbenzoate and some of its derivatives by Scedosporium apiospermum. Res. Microbiol. 1999, 150, 413–420. [Google Scholar] [CrossRef]
- García-Peña, E.I.; Hernández, S.; Favela-Torres, E.; Auria, R.; Revah, S. Toluene biofiltration by the fungus Scedosporium apiospermum TB1. Biotechnol. Bioeng. 2001, 76, 61–69. [Google Scholar] [CrossRef]
- Reyes-César, A.; Absalón, Á.E.; Fernández, F.J.; González, J.M.; Cortés-Espinosa, D.V. Biodegradation of a mixture of PAHs by non-ligninolytic fungal strains isolated from crude oil-contaminated soil. World J. Microbiol. Biotechnol. 2014, 30, 999–1009. [Google Scholar] [CrossRef]
- Ishii, K.; Furuichi, T.; Tanikawa, N.; Kuboshima, M. Estimation of the biodegradation rate of 2,3,7,8-tetrachlorodibenzo-p-dioxin by using dioxin-degrading fungus, Pseudallescheria boydii. J. Hazard. Mater. 2009, 162, 328–332. [Google Scholar] [CrossRef]
- Tigini, V.; Prigione, V.; Di Toro, S.; Fava, F.; Varese, G.C. Isolation and characterisation of polychlorinated biphenyl (PCB) degrading fungi from a historically contaminated soil. Microb. Cell Fact. 2009, 8, 5. [Google Scholar] [CrossRef]
- Mbokou, S.F.; Pontié, M.; Razafimandimby, B.; Bouchara, J.P.; Njanja, E.; Tonle, K.I. Evaluation of the degradation of acetaminophen by the filamentous fungus Scedosporium dehoogii using carbon-based modified electrodes. Anal. Bioanal. Chem. 2016, 408, 5895–5903. [Google Scholar] [CrossRef] [PubMed]
- Ren, H.; Li, H.; Wang, H.; Huang, H.; Lu, Z. Biodegradation of tetrahydrofuran by the newly isolated filamentous fungus Pseudallescheria boydii ZM01. Microorganisms 2020, 8, 1190. [Google Scholar] [CrossRef] [PubMed]
- Ribas, R.; Cazarolli, J.C.; da Silva, E.C.; Meneghetti, M.R.; Meneghetti, S.M.P.; Bento, F.M. Characterization of antimicrobial effect of organotin-based catalysts on diesel-biodiesel deteriogenic microorganisms. Environ. Monit. Assess. 2020, 192, 802. [Google Scholar] [CrossRef]
- Atakpa, E.O.; Zhou, H.; Jiang, L.; Ma, Y.; Liang, Y.; Li, Y.; Zhang, D.; Zhang, C. Improved degradation of petroleum hydrocarbons by co-culture of fungi and biosurfactant-producing bacteria. Chemosphere 2022, 290, 133337. [Google Scholar] [CrossRef] [PubMed]
- Martínez-Gallardo, M.R.; Jurado, M.M.; López-González, J.A.; Toribio, A.; Suárez-Estrella, F.; Sáez, J.A.; Moral, R.; Andreu-Rodríguez, F.J.; López, M.J. Biorecovery of olive mill wastewater sludge from evaporation ponds. J. Environ. Manag. 2022, 319, 115647. [Google Scholar] [CrossRef]
- Kumaravel, V.; Bankole, P.O.; Jooju, B.; Sadasivam, S.K. Degradation and detoxification of reactive yellow dyes by Scedosporium apiospermum: A mycoremedial approach. Arch. Microbiol. 2022, 204, 324. [Google Scholar] [CrossRef]
- Morales, L.T.; González-García, L.N.; Orozco, M.C.; Restrepo, S.; Vives, M.J. The genomic study of an environmental isolate of Scedosporium apiospermum shows its metabolic potential to degrade hydrocarbons. Stand. Genom. Sci. 2017, 12, 71. [Google Scholar] [CrossRef]
- Poirier, W.; Ravenel, K.; Bouchara, J.P.; Giraud, S. Lower funneling pathways in Scedosporium Species. Front. Microbiol. 2021, 12, 630753. [Google Scholar] [CrossRef]
- Janda-Ulfig, K.; Ulfig, K.; Cano, J.; Guarro, J. A study of the growth of Pseudallescheria boydii isolates from sewage sludge and clinical sources on tributyrin, rapeseed oil, biodiesel oil and diesel oil. Ann. Agric. Environ. Med. 2008, 15, 45–49. [Google Scholar]
- Berthon, J.Y.; Grizard, D. Fungal Inoculum, Method for Its Preparation and Methods for Its Utilization for the Treatment of Waste Water with High Content in Organic Material. European Patent EP 1352953, 15 October 2003. [Google Scholar]
- Nomoto, T. Promoter for Composting. Japan Patent JP 3485345, 25 August 2003. [Google Scholar]
- Laugero, C.; Tillier, D. Method for Biological Treatment of Animal Breeding Effluent and Device Therefor. European Patent EP 1242318, 9 October 2001. [Google Scholar]
- Santos, A.L.S.; Bittencourt, V.C.; Pinto, M.R.; Silva, B.A.; Barreto-Bergter, E. Biochemical characterization of potential virulence markers in the human fungal pathogen Pseudallescheria boydii. Med. Mycol. 2009, 47, 375–386. [Google Scholar] [CrossRef]

| Species | Molecule/Compound | References |
|---|---|---|
| S. boydii | n-Alkanes | [155] |
| S. boydii | 1-Alkenes | [155] |
| S. boydii | Hydrocarbons | [155,165] |
| S. apiospermum | Phenol | [156] |
| S. apiospermum | p-Cresol | [156] |
| S. apiospermum | 4-Hydroxybenzoate | [156] |
| S. apiospermum | 4-Hydroxybenzaldehyde | [156] |
| S. apiospermum | 4-Hydroxybenzylalcohol | [156] |
| S. apiospermum | Protocatechuate | [156] |
| S. apiospermum | Phenylbenzoate | [157] |
| S. apiospermum | p-Tolylbenzoate | [157] |
| S. apiospermum | 4-Chlorophenylbenzoate | [157] |
| S. apiospermum | Toluene | [158] |
| S. boydii | Rapeseed oil | [168] |
| S. boydii | Biodiesel | [83,84,168] |
| S. boydii | Diesel oil | [84,168] |
| S. boydii | 2,3,7,8-Tetrachlorodibenzo-p-dioxin | [160] |
| S. apiospermum | Polychlorinated biphenyl | [161] |
| S. apiospermum | Polycyclic aromatic hydrocarbons | [159] |
| S. dehoogii | Acetaminophen | [162] |
| S. boydii | Diesel blend | [84] |
| S. boydii | Tetrahydrofuran | [163] |
| S. boydii | Dibutyl tin dilaurate | [164] |
| S. boydii | Di-n-butyl-oxo-stannane | [164] |
| Scedosporium spp. | Lignin | [169] |
| S. apiospermum | Olive mill wastewater | [166] |
| S. apiospermum | Reactive Yellow 145 | [167] |
| S. apiospermum | Remazol Yellow RR | [167] |
Publisher’s Note: MDPI stays neutral with regard to jurisdictional claims in published maps and institutional affiliations. |
© 2022 by the authors. Licensee MDPI, Basel, Switzerland. This article is an open access article distributed under the terms and conditions of the Creative Commons Attribution (CC BY) license (https://creativecommons.org/licenses/by/4.0/).
Share and Cite
Mello, T.P.; Barcellos, I.C.; Aor, A.C.; Branquinha, M.H.; Santos, A.L.S. Extracellularly Released Molecules by the Multidrug-Resistant Fungal Pathogens Belonging to the Scedosporium Genus: An Overview Focused on Their Ecological Significance and Pathogenic Relevance. J. Fungi 2022, 8, 1172. https://doi.org/10.3390/jof8111172
Mello TP, Barcellos IC, Aor AC, Branquinha MH, Santos ALS. Extracellularly Released Molecules by the Multidrug-Resistant Fungal Pathogens Belonging to the Scedosporium Genus: An Overview Focused on Their Ecological Significance and Pathogenic Relevance. Journal of Fungi. 2022; 8(11):1172. https://doi.org/10.3390/jof8111172
Chicago/Turabian StyleMello, Thaís P., Iuri C. Barcellos, Ana Carolina Aor, Marta H. Branquinha, and André L. S. Santos. 2022. "Extracellularly Released Molecules by the Multidrug-Resistant Fungal Pathogens Belonging to the Scedosporium Genus: An Overview Focused on Their Ecological Significance and Pathogenic Relevance" Journal of Fungi 8, no. 11: 1172. https://doi.org/10.3390/jof8111172
APA StyleMello, T. P., Barcellos, I. C., Aor, A. C., Branquinha, M. H., & Santos, A. L. S. (2022). Extracellularly Released Molecules by the Multidrug-Resistant Fungal Pathogens Belonging to the Scedosporium Genus: An Overview Focused on Their Ecological Significance and Pathogenic Relevance. Journal of Fungi, 8(11), 1172. https://doi.org/10.3390/jof8111172

